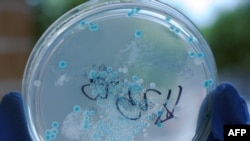
Чашка Петри с посевом бактерий E.сoli

«В Армении в настоящее время ситуация спокойная, у нас таких случаев нет, - в беседе с Радио Азатутюн заявил начальник инспекции государственного гигиенического и противоэпидемического надзора Министерства здравоохранения Артавазд Ванян и добавил: - Однако, конечно, бдительность повышена. С нашей стороны также был установлен контроль. Если среди пассажиров, которые прибывают в Ереван, будут зафиксированы подобные случаи, то они сразу же будут взяты под контроль».
Между тем, главный инфекционист Армении Ара Асоян сообщил Радио Азатутюн, что, по всей вероятности, случаи заражения инфекцией E.coli в Армении были зарегистрированы еще в прошлом году. «Честно говоря, у меня сложилось впечатление, что в прошлом году у нас было несколько подобных случаев. Мы очень хорошо поработали, поработали совместно со специалистами ряда других больниц, провели инструментальное вмешательство... У этих больных были поражены почки... Я считаю, что у нас было несколько подобных случаев, потому что этот возбудитель нам известен», - отметил он.
По данным Всемирной организации здравоохранения (ВОЗ), от кишечной инфекции E.coli в Европе умерло 25 человек. Болезнь была обнаружена примерно у 2 тысяч человек.
Вначале в качестве источника заражения кишечной палочкой E.coli считались огурцы, выращенные в Испании, однако эта версия в дальнейшем не подтвердилась. Сейчас под подозрение попала проросшая соя.
Только в Гамбурге, согласно ВОЗ, число заболевших достигло 1700 человек, у 570 из них врачи зафиксировали симптомы, угрожающие жизни. Первоначальным источником инфекции, предположительно, является ферма Ульцен недалеко от Гамбурга.
Между тем, главный инфекционист Армении Ара Асоян сообщил Радио Азатутюн, что, по всей вероятности, случаи заражения инфекцией E.coli в Армении были зарегистрированы еще в прошлом году. «Честно говоря, у меня сложилось впечатление, что в прошлом году у нас было несколько подобных случаев. Мы очень хорошо поработали, поработали совместно со специалистами ряда других больниц, провели инструментальное вмешательство... У этих больных были поражены почки... Я считаю, что у нас было несколько подобных случаев, потому что этот возбудитель нам известен», - отметил он.
По данным Всемирной организации здравоохранения (ВОЗ), от кишечной инфекции E.coli в Европе умерло 25 человек. Болезнь была обнаружена примерно у 2 тысяч человек.
Вначале в качестве источника заражения кишечной палочкой E.coli считались огурцы, выращенные в Испании, однако эта версия в дальнейшем не подтвердилась. Сейчас под подозрение попала проросшая соя.
Только в Гамбурге, согласно ВОЗ, число заболевших достигло 1700 человек, у 570 из них врачи зафиксировали симптомы, угрожающие жизни. Первоначальным источником инфекции, предположительно, является ферма Ульцен недалеко от Гамбурга.